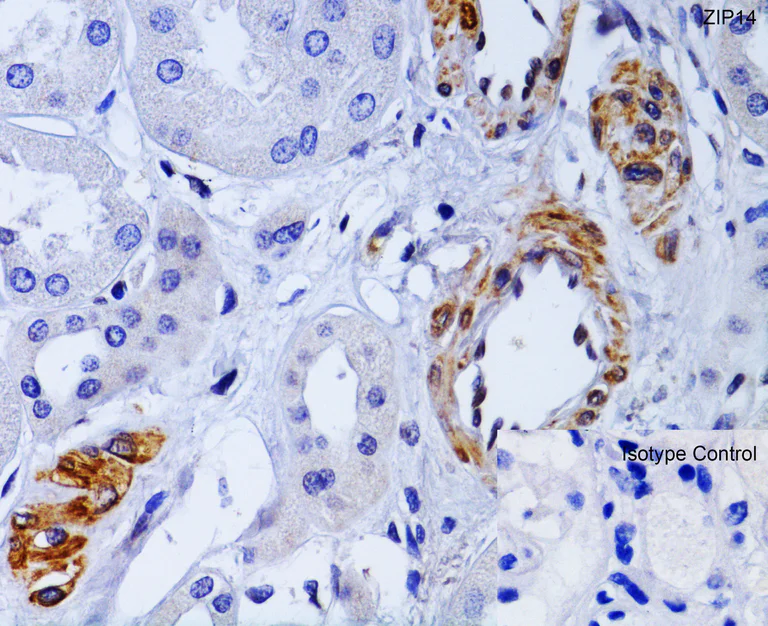
Anti-SLC39A14/ZIP-14 antibody (ab106568) | Abcam

マイストア
変更
お店で受け取る
(送料無料)
配送する
納期目安:
2026.02.22 10:58頃のお届け予定です。
決済方法が、クレジット、代金引換の場合に限ります。その他の決済方法の場合はこちらをご確認ください。
※土・日・祝日の注文の場合や在庫状況によって、商品のお届けにお時間をいただく場合がございます。
ARS10+ SP インプラカブル AR8132A - Combination Lock Handles (Qty 2) for NetShelter SX / SVの詳細情報
AR8132A - Combination Lock Handles (Qty 2) for NetShelter SX / SV。Ingersoll IN1310SL Brandenburg Gate Sapphire Crystal 44mm。Anti-SLC39A14/ZIP-14 antibody (ab106568) | Abcam。製品写真/AX8308S:アラクサラネットワークス株式会社。最高評価です#露光の鑑定品アズールレーン種別...シングルカード
ベストセラーランキングです
近くの売り場の商品
カスタマーレビュー
オススメ度 4点
現在、2820件のレビューが投稿されています。